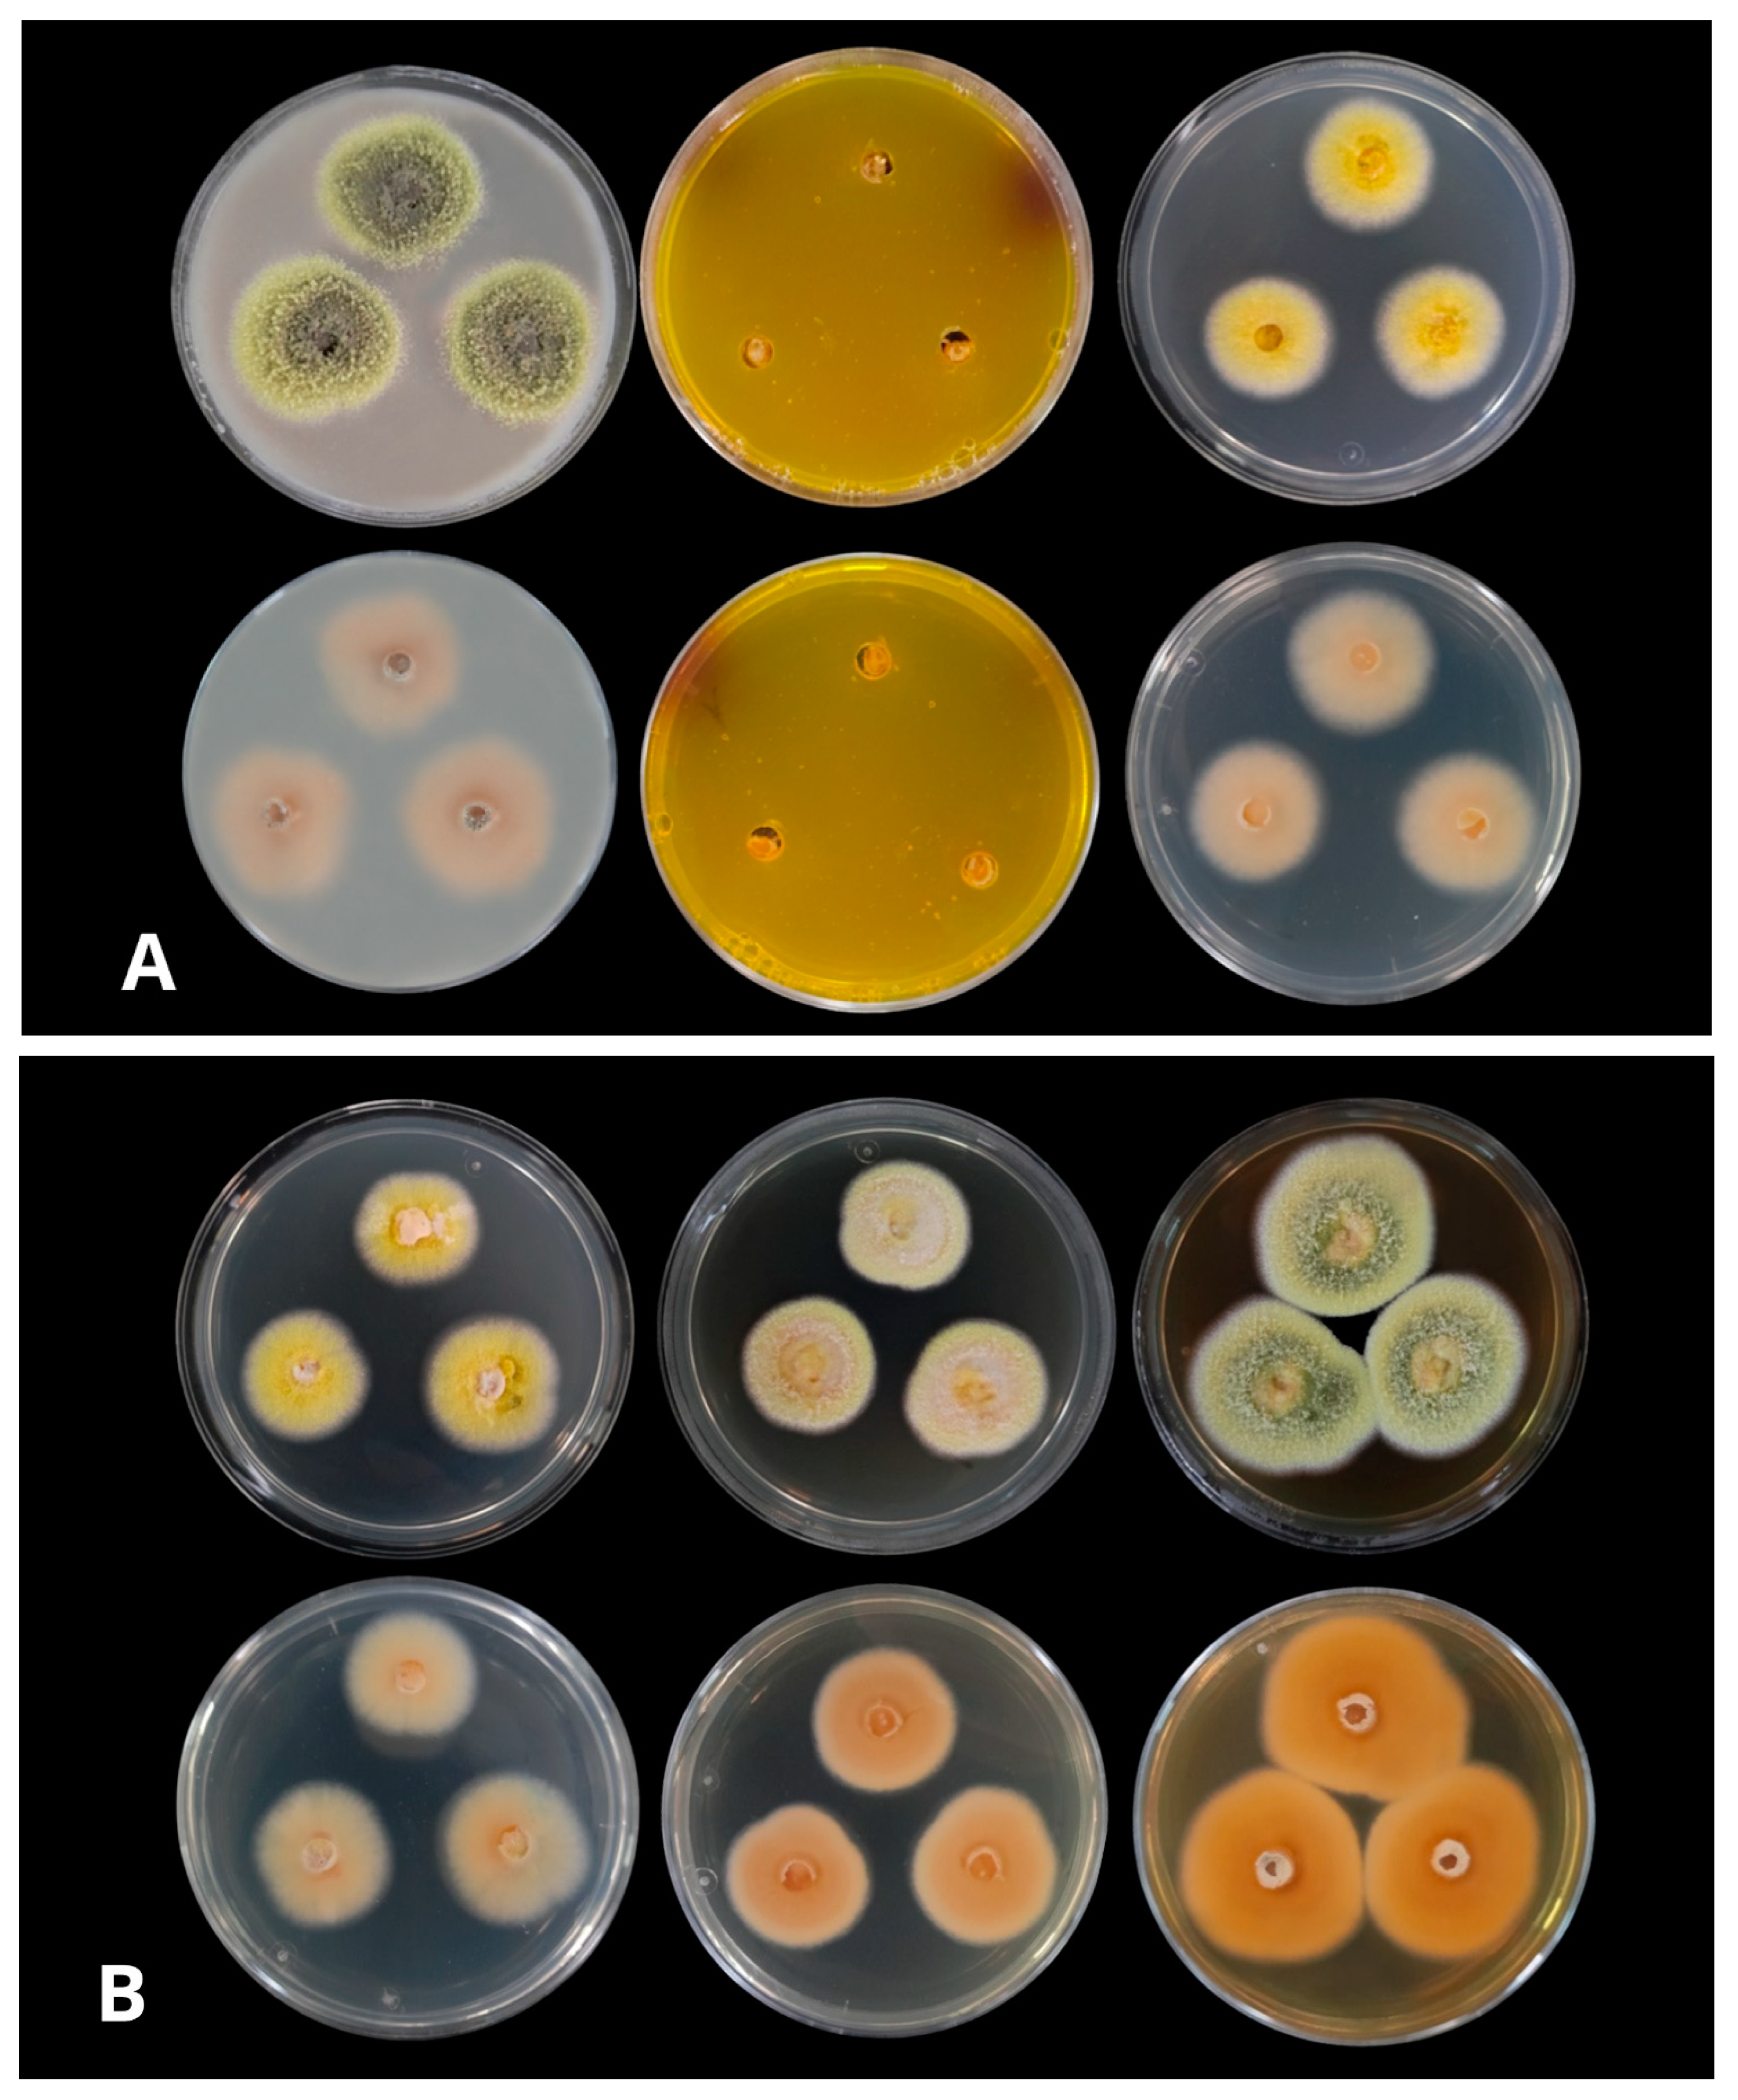
Jof 08 01042 g002

Talaromyces santanderensis: A New Cadmium-Tolerant Fungus from Cacao Soils in Colombia
Abstract
1. Introduction
2. Materials and Methods
2.1. Sample Soil Description
2.2. Isolation of Strains and Screening for Cadmium Tolerant Fungi
2.3. Cadmium Tolerance Test
2.4. Cultivation Conditions and Colony Morphology
2.5. Microscopic Identification
2.6. DNA Extraction and Amplification
2.7. Molecular Characterization and Phylogeny
3. Results
3.1. Description of New Taxa
3.2. Cadmium Tolerance Test
3.3. Growth in Different Culture Media
3.4. Micromorphology Analysis
3.5. Molecular Identification and Sequence Analysis
3.6. Phylogenetic Analysis
4. Discussion
Supplementary Materials
Author Contributions
Funding
Institutional Review Board Statement
Informed Consent Statement
Data Availability Statement
Acknowledgments
Conflicts of Interest
Legal Considerations
References
- Riaz, M.; Kamran, M.; Fang, Y.; Wang, Q.; Cao, H.; Yang, G.; Deng, L.; Wang, Y.; Zhou, Y.; Anastopoulos, I.; et al. Arbuscular mycorrhizal fungi-induced mitigation of heavy metal phytotoxicity in metal contaminated soils: A critical review. J. Hazard. Mater. 2021, 402, 123919. [Google Scholar] [CrossRef]
- Bertoldi, D.; Barbero, A.; Camin, F.; Caligiani, A.; Larcher, R. Multielemental fingerprinting and geographic traceability of Theobroma cacao beans and cocoa products. Food Control 2016, 65, 46–53. [Google Scholar] [CrossRef]
- Possú, W.B.; Navia, J.F.; Solarte, J.G. Socio-economic characterization of the traditional cacao agroforestry system (Theobroma cacao L.). Rev. Cienc. Agríc. 2021, 38, 17–35. [Google Scholar] [CrossRef]
- Ramtahal, G.; Yen, I.C.; Ahmad, N.; Bekele, I.; Bekele, F.; Maharaj, K.; Wilson, L.; Harrynanan, L. Prediction of Soil Cadmium Bioavailability to Cacao (Theobroma cacao L.) using Single-Step Extraction Procedures. Commun. Soil Sci. Plant Anal. 2015, 46, 2585–2594. [Google Scholar] [CrossRef]
- Das, S.C.; Al-Naemi, H.A. Cadmium Toxicity: Oxidative Stress, Inflammation and Tissue Injury. Occup. Dis. Environ. Med. 2019, 7, 144–163. [Google Scholar] [CrossRef]
- Ramtahal, G.; Yen, I.C.; Hamid, A.; Bekele, I.; Bekele, F.; Maharaj, K.; Harrynanan, L. The Effect of Liming on the Availability of Cadmium in Soils and Its Uptake in Cacao (Theobroma cacao L.) Trinidad & Tobago. Commun. Soil Sci. Plant Anal. 2018, 49, 2456–2464. [Google Scholar] [CrossRef]
- Kabata-Pendias, A. Trace Elements in Soils and Plants, 3rd ed.; CRC Press: Boca Raton, FL, USA, 2000; ISBN 978-0-429-19112-1. [Google Scholar]
- Echeverry, A.; Reyes, H. Determinación de La Concentración de Cadmio En Un Chocolate Colombiano Con 65% de Cacao y Chocolates Extranjeros Con Diferentes Porcentajes de Cacao. Entre Cienc. Ing. 2016, 10, 22–32. [Google Scholar]
- European Union. Commission Regulation (EU) No 488/2014 of 12 May 2014 Amending Regulation (EC) No 1881/2006 as Regards Maximum Levels of Cadmium in Foodstuffs. J. Eur. Union. 2014. Available online: https://eur–lex.europa.eu/legal–content/EN/TXT/?uri=celex:32014R0488 (accessed on 30 July 2022).
- Colombian Ministry of Agriculture and Rural Development. CADENA DE CACAO. Dirección de Cadenas Agrícolas y Forestales. 2019. Available online: https://sioc.minagricultura.gov.co/Cacao/Documentos/2019–06–30%20Cifras%20Sectoriales.pdf (accessed on 28 March 2022).
- Bravo, D.; Leon-Moreno, C.; Martínez, C.; Varón-Ramírez, V.; Araujo-Carrillo, G.; Vargas, R.; Quiroga-Mateus, R.; Zamora, A.; Rodríguez, E. The First National Survey of Cadmium in Cacao Farm Soil in Colombia. Agronomy 2021, 11, 761. [Google Scholar] [CrossRef]
- Bandurska, K.; Krupa, P.; Berdowska, A.; Jatulewicz, I.; Zawierucha, I. Mycoremediation of Soil Contaminated with Cadmium and Lead by Trichoderma sp. Ecol. Chem. Eng. 2021, 28, 277–286. [Google Scholar] [CrossRef]
- Văcar, C.; Covaci, E.; Chakraborty, S.; Li, B.; Weindorf, D.; Frențiu, T.; Pârvu, M.; Podar, D. Heavy Metal-Resistant Filamentous Fungi as Potential Mercury Bioremediators. J. Fungi 2021, 7, 386. [Google Scholar] [CrossRef] [PubMed]
- Maini, Z.A.N.; Aribal, K.M.J.; Narag, R.M.A.; Melad, J.K.L.T.; Frejas, J.A.D.; Arriola, L.A.M.; Gulpeo, P.C.R.; Navarrete, I.A.; Lopez, C.M. Lead (II) Tolerance and Uptake Capacities of Fungi Isolated from a Polluted Tributary in the Philippines. Appl. Environ. Biotechnol. 2019, 4, 18–29. [Google Scholar] [CrossRef][Green Version]
- Oladipo, O.G.; Awotoye, O.O.; Olayinka, A.; Bezuidenhout, C.C.; Maboeta, M.S. Heavy metal tolerance traits of filamentous fungi isolated from gold and gemstone mining sites. Braz. J. Microbiol. 2018, 49, 29–37. [Google Scholar] [CrossRef]
- Mohammadian, E.; Ahari, A.B.; Arzanlou, M.; Oustan, S.; Khazaei, S.H. Tolerance to heavy metals in filamentous fungi isolated from contaminated mining soils in the Zanjan Province, Iran. Chemosphere 2017, 185, 290–296. [Google Scholar] [CrossRef]
- Fazli, M.M.; Soleimani, N.; Mehrasbi, M.; Darabian, S.; Mohammadi, J.; Ramazani, A. Highly cadmium tolerant fungi: Their tolerance and removal potential. J. Environ. Health Sci. Eng. 2015, 13, 19. [Google Scholar] [CrossRef]
- Ezzouhri, L.; Castro, E.; Moya, M.; Espinola, F.; Lairini, K. Heavy Metal Tolerance of Filamentous Fungi Isolated from Polluted Sites in Tangier, Morocco. Afr. J. Microbiol. Res. 2009, 3, 35–48. [Google Scholar]
- El-Shafey, N.M.; Marzouk, M.A.; Yasser, M.M.; Shaban, S.A.; Beemster, G.T.; AbdElgawad, H. Harnessing Endophytic Fungi for Enhancing Growth, Tolerance and Quality of Rose-Scented Geranium (Pelargonium graveolens (L’Hér) Thunb.) Plants under Cadmium Stress: A Biochemical Study. J. Fungi 2021, 7, 1039. [Google Scholar] [CrossRef]
- El-Shahir, A.A.; El-Tayeh, N.A.; Ali, O.M.; Latef, A.A.H.A.; Loutfy, N. The Effect of Endophytic Talaromyces pinophilus on Growth, Absorption and Accumulation of Heavy Metals of Triticum aestivum Grown on Sandy Soil Amended by Sewage Sludge. Plants 2021, 10, 2659. [Google Scholar] [CrossRef]
- Bengtsson, L.; Johansson, B.; Hackett, T.J.; McHale, L.; McHale, A.P. Studies on the biosorption of uranium by Talaromyces emersonii CBS 814.70 biomass. Appl. Microbiol. Biotechnol. 1995, 42, 807–811. [Google Scholar] [CrossRef]
- Coelho, E.; Reis, T.A.; Cotrim, M.; Mullan, T.K.; Renshaw, J.; Rizzutto, M.; Corrêa, B. Talaromyces amestolkiae uses organic phosphate sources for the treatment of uranium-contaminated water. BioMetals 2022, 35, 335–348. [Google Scholar] [CrossRef]
- Massaccesi, G.; Romero, M.C.; Cazau, M.C.; Bucsinszky, A.M. Cadmium removal capacities of filamentous soil fungi isolated from industrially polluted sediments, in La Plata (Argentina). World J. Microbiol. Biotechnol. 2002, 18, 817–820. [Google Scholar] [CrossRef]
- Romero, M.C.; Reinoso, E.H.; Urrutia, M.I.; Kiernan, A.M. Biosorption of heavy metals by Talaromyces helicus: A trained fungus for copper and biphenyl detoxification. Electron. J. Biotechnol. 2006, 9, 3. [Google Scholar] [CrossRef]
- Sharma, P.; Singh, S.P. Role of the Endogenous Fungal Metabolites in the Plant Growth Improvement and Stress Tolerance. In Fungi Bio–Prospects in Sustainable Agriculture, Environment and Nano–technology; Elsevier: Amsterdam, The Netherlands, 2021; pp. 381–401. [Google Scholar] [CrossRef]
- Yilmaz, N.; Visagie, C.; Houbraken, J.; Frisvad, J.; Samson, R. Polyphasic taxonomy of the genus Talaromyces. Stud. Mycol. 2014, 78, 175–341. [Google Scholar] [CrossRef] [PubMed]
- Sun, B.-D.; Chen, A.J.; Houbraken, J.; Frisvad, J.; Wu, W.-P.; Wei, H.-L.; Zhou, Y.-G.; Jiang, X.-Z.; Samson, R.A. New section and species in Talaromyces. MycoKeys 2020, 68, 75–113. [Google Scholar] [CrossRef]
- Crous, P.W.; Gams, W.; Stalpers, J.A.; Robert, V.; Stegehuis, G. MycoBank: An Online Initiative to Launch Mycology into the 21st Century. Stud. Mycol. 2004, 50, 19–22. [Google Scholar]
- Wang, X.-C.; Zhuang, W.-Y. New Species of Talaromyces (Trichocomaceae, Eurotiales) from Southwestern China. J. Fungi 2022, 8, 647. [Google Scholar] [CrossRef]
- Peterson, S.W.; Jurjević, Ž. The Talaromyces pinophilus species complex. Fungal Biol. 2019, 123, 745–762. [Google Scholar] [CrossRef] [PubMed]
- Samson, R.; Yilmaz, N.; Houbraken, J.; Spierenburg, H.; Seifert, K.; Peterson, S.; Varga, J.; Frisvad, J. Phylogeny and nomenclature of the genus Talaromyces and taxa accommodated in Penicillium subgenus Biverticillium. Stud. Mycol. 2011, 70, 159–183. [Google Scholar] [CrossRef]
- Visagie, C.; Hirooka, Y.; Tanney, J.; Whitfield, E.; Mwange, K.; Meijer, M.; Amend, A.; Seifert, K.; Samson, R. Isolated from house dust samples collected around the world. Stud. Mycol. 2014, 78, 63–139. [Google Scholar] [CrossRef]
- Ridgway, R. Color Standards and Color Nomenclature; Washington, DC, USA, 1912; Available online: https://library.si.edu/digital–library/book/colorstandardsc00ridg (accessed on 28 March 2022).
- Chi, M.-H.; Park, S.-Y.; Lee, Y.-H. A Quick and Safe Method for Fungal DNA Extraction. Plant Pathol. J. 2009, 25, 108–111. [Google Scholar] [CrossRef]
- Liu, Y.J.; Whelen, S.; Hall, B.D. Phylogenetic relationships among ascomycetes: Evidence from an RNA polymerse II subunit. Mol. Biol. Evol. 1999, 16, 1799–1808. [Google Scholar] [CrossRef] [PubMed]
- Matheny, P.B. Improving phylogenetic inference of mushrooms with RPB1 and RPB2 nucleotide sequences (Inocybe; Agaricales). Mol. Phylogenet. Evol. 2005, 35, 1–20. [Google Scholar] [CrossRef] [PubMed]
- O’Donnell, K.; Cigelnik, E. Two Divergent Intragenomic rDNA ITS2 Types within a Monophyletic Lineage of the Fungus Fusarium Are Nonorthologous. Mol. Phylogenet. Evol. 1997, 7, 103–116. [Google Scholar] [CrossRef]
- Rausch, T.; Fritz, M.H.-Y.; Untergasser, A.; Benes, V. Tracy: Basecalling, alignment, assembly and deconvolution of sanger chromatogram trace files. BMC Genom. 2020, 21, 230. [Google Scholar] [CrossRef]
- Katoh, K.; Asimenos, G.; Toh, H. Multiple Alignment of DNA Sequences with MAFFT. In Bioinformatics for DNA Sequence Analysis; Posada, D., Ed.; Humana Press: Totowa, NJ, USA, 2009; pp. 39–64. ISBN 978-1-59745-251-9. [Google Scholar]
- Nguyen, L.-T.; Schmidt, H.A.; Von Haeseler, A.; Minh, B.Q. IQ-TREE: A Fast and Effective Stochastic Algorithm for Estimating Maximum-Likelihood Phylogenies. Mol. Biol. Evol. 2014, 32, 268–274. [Google Scholar] [CrossRef] [PubMed]
- Bouckaert, R.; Heled, J.; Kühnert, D.; Vaughan, T.; Wu, C.-H.; Xie, D.; Suchard, M.A.; Rambaut, A.; Drummond, A.J. BEAST 2: A Software Platform for Bayesian Evolutionary Analysis. PLoS Comput. Biol. 2014, 10, e1003537. [Google Scholar] [CrossRef]
- Meddings, J.B.; Scott, R.B.; Fick, G.H. Analysis and comparison of sigmoidal curves: Application to dose-response data. Am. Am. J. Physiol.—Gastrointest. Liver Physiol. 1989, 257, G982–G989. [Google Scholar] [CrossRef]
- Houbraken, J.; de Vries, R.P.; Samson, R.A. Modern Taxonomy of Biotechnologically Important Aspergillus and Penicillium Species. Adv. Appl. Microbiol 2014, 86, 199–249. [Google Scholar] [CrossRef]
- Fujii, T.; Hoshino, T.; Inoue, H.; Yano, S. Taxonomic Revision of the Cellulose–Degrading Fungus Acremonium Cellulolyticus Nomen Nudum to Talaromyces Based on Phylogenetic Analysis. FEMS Microbiol. Lett. 2014, 351, 32–41. [Google Scholar] [CrossRef]
- Chen, A.; Sun, B.; Houbraken, J.; Frisvad, J.; Yilmaz, N.; Zhou, Y.; Samson, R. New Talaromyces species from indoor environments in China. Stud. Mycol. 2016, 84, 119–144. [Google Scholar] [CrossRef]
- Jiang, X.-Z.; Yu, Z.-D.; Ruan, Y.-M.; Wang, L. Three New Species of Talaromyces Sect. Talaromyces Discovered from Soil in China. Sci. Rep. 2018, 8, 4932. [Google Scholar] [CrossRef] [PubMed]
- Böhm, J.; Hoff, B.; O’Gorman, C.M.; Wolfers, S.; Klix, V.; Binger, D.; Zadra, I.; Kürnsteiner, H.; Pöggeler, S.; Dyer, P.S.; et al. Sexual reproduction and mating-type–mediated strain development in the penicillin-producing fungus Penicillium chrysogenum. Proc. Natl. Acad. Sci. USA 2013, 110, 1476–1481. [Google Scholar] [CrossRef] [PubMed]
- Ropars, J.; Dupont, J.; Fontanillas, E.; de la Vega, R.C.R.; Malagnac, F.; Coton, M.; Giraud, T.; López-Villavicencio, M. Sex in Cheese: Evidence for Sexuality in the Fungus Penicillium Roqueforti. PLoS ONE 2012, 7, e49665. [Google Scholar] [CrossRef] [PubMed]
- Zhang, Z.-K.; Wang, X.-C.; Zhuang, W.-Y.; Cheng, X.-H.; Zhao, P. New Species of Talaromyces (Fungi) Isolated from Soil in Southwestern China. Biology 2021, 10, 745. [Google Scholar] [CrossRef]
- Ruta, L.; Paraschivescu, C.; Matache, M.; Avramescu, S.; Farcasanu, I.C. Removing heavy metals from synthetic effluents using “kamikaze” Saccharomyces cerevisiae cells. Appl. Microbiol. Biotechnol. 2009, 85, 763–771. [Google Scholar] [CrossRef]
- Urik, M. Interactions of Toxic Metals and Metaloids with Fungi. Ph.D. Thesis, Faculty of Chemistry, Brno University of Technology, Brno, Czech Republic, 2018. [Google Scholar]
- Kumar, V.; Dwivedi, S.K. Mycoremediation of heavy metals: Processes, mechanisms, and affecting factors. Environ. Sci. Pollut. Res. 2021, 28, 10375–10412. [Google Scholar] [CrossRef]
- Khan, I.; Aftab, M.; Shakir, S.; Ali, M.; Qayyum, S.; Rehman, M.U.; Haleem, K.S.; Touseef, I. Mycoremediation of heavy metal (Cd and Cr)–polluted soil through indigenous metallotolerant fungal isolates. Environ. Monit. Assess. 2019, 191, 585. [Google Scholar] [CrossRef]
- Purohit, J.; Chattopadhyay, A.; Biswas, M.K.; Singh, N.K. Mycoremediation of Agricultural Soil: Bioprospection for Sustainable Development. In Fungal Biology; Springer International Publishing: Berlin/Heidelberg, Germany, 2018; pp. 91–120. [Google Scholar]

| Gene | Sequence (5′-3′) | Annealing Temperature (°C) | Size (bp) |
|---|---|---|---|
| ITS | Forward: ITS1-F (TCCGTAGGTGAACCTGCGG) Reverse: ITS4-R (TCCTCCGCTTATTGATATGC) | 55 °C | 500 bp |
| CaM | Forward: CMD5 (CCGAGTACAAGGARGCCTTC) Reverse: CMD6 (CCGATRGAGGTCATRACGTGG) | 50 °C | 600 bp |
| RPB2 | Forward: RPB2-5F (CCRAARTGATCWCKRTCRTC) Reverse: bRPB2-7.1R (CCCATRGCYTGYTTMCCCATDGC) | 52.5 °C | 1000 bb |
| BenA | Forward: T1 (AACATGCGTGAGATTGTAAG) Reverse: T22 (TCTGGATGTTGTTGGGAATCC) | 55.4 °C | 1350 bp |
| Species | CYA mm | MEA mm | YES mm | Conidiophore | Conidia Shape | Conidia Wall | Conidia Size-μm | Source |
|---|---|---|---|---|---|---|---|---|
| T. santanderensis | 22–24 | 34–36 | 26–30 | Mono-to biverticillate | Slightly globose | Smooth | 1.8–2.2 | Cocoa soil, Santander, Colombia |
| T. pinophilusa | 16–31 | 37–45 | 12–35 | Biverticillate, occasionally monoverticillate | Subglobose to ellipsoidal | Smooth to finely roughened | 2.5–3.5 (−9) ×2.5–3.0 (−5) | PVC, France |
| T. adpressus b | 32–33 | 42–43 | 42–43 | Biverticillate | Subglobose to ellipsoidal | Smooth | 2.5–4.5 (−4.5) × 2–3.5 | Indoor environments in Beijing China |
| T. lentulusc | 26–27 | 43–44 | 37–38 | Biverticillate | Globose | Smooth | 2.5–3.0 | Alkaline soil, Yingkou, Shandong, China |
| T. pratensisd | 20–22 | 34–36 | NI | Biverticillate, occasionally monoverticillate | Globose to subglobose, occasionally broadly ellipsoidal | Smooth to finely roughened walls | 2.5–3.0 (−7)× 2.5–3.5 (−4.5) | Effluent of water treatment plant Cincinnati, W. B. |
| T. solid | 20–26 | 37–42 | Biverticillate rarely monoverticillate | Subglobose to broadly ellipsoidal | Thick, to finely roughened | 2.5–3.5 (−5.5) × 2.5–3.5 (−4.5) | Isolated from soil. | |
| T. tumulid | 19–27 | 36–42 | Biverticillate rarely monoverticillate | Subglobose to broadly ellipsoidal | Smooth to finely roughened walls | 2.5–3.5 (−7) 2.5–3.5 (−4.5) | Isolated from soil from the big bluestem prairie |
Publisher’s Note: MDPI stays neutral with regard to jurisdictional claims in published maps and institutional affiliations. |
© 2022 by the authors. Licensee MDPI, Basel, Switzerland. This article is an open access article distributed under the terms and conditions of the Creative Commons Attribution (CC BY) license (https://creativecommons.org/licenses/by/4.0/).
Share and Cite
Guerra Sierra, B.E.; Arteaga-Figueroa, L.A.; Sierra-Pelaéz, S.; Alvarez, J.C. Talaromyces santanderensis: A New Cadmium-Tolerant Fungus from Cacao Soils in Colombia. J. Fungi 2022, 8, 1042. https://doi.org/10.3390/jof8101042
Guerra Sierra BE, Arteaga-Figueroa LA, Sierra-Pelaéz S, Alvarez JC. Talaromyces santanderensis: A New Cadmium-Tolerant Fungus from Cacao Soils in Colombia. Journal of Fungi. 2022; 8(10):1042. https://doi.org/10.3390/jof8101042
Chicago/Turabian StyleGuerra Sierra, Beatriz E., Luis A. Arteaga-Figueroa, Susana Sierra-Pelaéz, and Javier C. Alvarez. 2022. "Talaromyces santanderensis: A New Cadmium-Tolerant Fungus from Cacao Soils in Colombia" Journal of Fungi 8, no. 10: 1042. https://doi.org/10.3390/jof8101042
APA StyleGuerra Sierra, B. E., Arteaga-Figueroa, L. A., Sierra-Pelaéz, S., & Alvarez, J. C. (2022). Talaromyces santanderensis: A New Cadmium-Tolerant Fungus from Cacao Soils in Colombia. Journal of Fungi, 8(10), 1042. https://doi.org/10.3390/jof8101042

